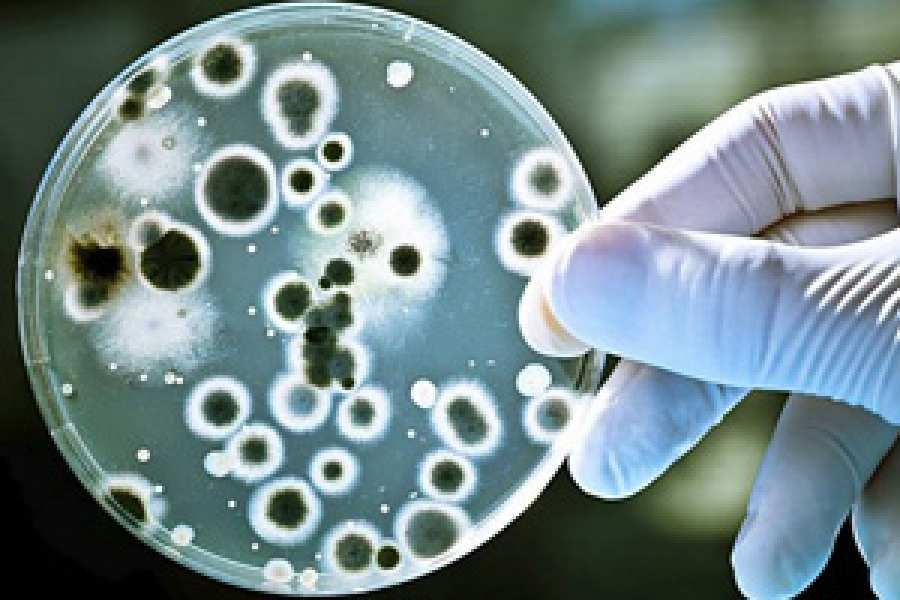
Una investigaci&oacute;n del IBR publicada en una revista de prestigio internacional abre las puertas al dise&ntilde;o de nuevos f&aacute;rmacos para vencer infecciones letales

Mostrando artículos por etiqueta: Investigación
Dos científicas argentinas lideran investigaciones para entender cómo se propaga el cáncer
En el día mundial de lucha contra el cáncer de mama, vale destacar el trabajo de dos científicas argentinas que buscan entender, una desde la Argentina, la otra desde los Estados Unidos, cómo las células cancerosas muchas veces logran resistir o escapar del ataque de la quimioterapia u otros tratamientos.
Con investigaciones diferentes, pero con un objetivo común, Vanesa Gottifredi y Sofia Merajver, buscan identificar, para luego poder atacar, el comportamiento de las células malignas para expandir su daño.
Tras el mecanismo de adaptación de las células malignas
¿Qué mecanismo de adaptación utilizan las células malignas en su proceso de replicación para evadir el efecto de la quimioterapia? Las investigaciones en torno a pregunta clave, además de su trayectoria, le valieron a la científica argentina Vanesa Gottifredi el premio Friedrich Wilhelm Bessel que otorga la prestigiosa Fundación Alexander von Humboldt de Alemania.
Gottifredi, oriunda de Salta, es jefa del Laboratorio de Ciclo Celular y Estabilidad Genómica del Instituto de Investigaciones Bioquímicas de Buenos Aires (IIBBA) que depende de la Fundación Instituto Leloir y del CONICET.
“El conocimiento es algo que se obtiene en forma randomizada. Es muy difícil de ordenar. Y buscar entre lo que no se conoce, es mucho más caótico. En cáncer no sabemos lo suficiente”, explica a Clarín Gottifredi, que se graduó en química en la Universidad Nacional de Salta y se doctoró en biología humana en la Universidad “La Sapienza” de Roma, Italia.
Su desafío es entender el proceso de replicación del ADN y su rol en el cáncer. La célula tumoral busca dividirse, explica la científica. Para ello, cada célula debe copiar el código (o receta) de ADN que tiene en su núcleo. La quimioterapia actúa arruinando la calidad del ADN que debe ser copiado, de forma que esa réplica sea tan mala que ya no sirva para generar una célula viva.
“Pero, tenemos un ADN inestable, y que necesita replicarse y mutar como parte de la evolución. El cáncer es un efecto colateral de esa capacidad mutagénica, que es necesaria para la evolución, porque sin eso hoy no estaríamos acá. El ADN es inestable para poder generar un organismo distinto”, afirma.
“La célula humana, para lidiar con agentes tóxicos como la radiación del sol, posee procesos que adaptan el copiado de ADN a moldes imperfectos. Y la célula tumoral, en muchos casos, aprovecha esos mecanismos logrando algunas copias que permiten la sobrevida de algunas células malignas y, después de un tiempo, vuelven a generar la enfermedad”, explica Gottifredi.
Con su equipo, Gottifredi trata de entender este proceso para encontrar nuevos tratamientos. “El objetivo es encontrar nuevos blancos terapéuticos”, acota. Las investigaciones enmarcadas en este premio es producir conocimiento útil para la sociedad y apuntar a potenciales herramientas con capacidad de mejorar las terapias actuales.
Gottifredi trabaja junto a la doctora Lisa Weissmuller, jefa del Departamento de Obstetricia y Ginecología de la Universidad de Ulm, Alemania, líder en el campo de la identificación de biomarcadores de riesgo de cáncer. Precisamente, la oncogénesis es para la investigadora argentina una de las líneas más prometedoras en lo que a prevención del cáncer se refiere. “La oncogénesis es lo que en el futuro vamos a estar intentando tratar. Esto es, evitar la génesis. Si en un futuro pudieras tomar una pastilla que te mantenga a raya las células que cambian, sería magnífico. La clave es el conocimiento, si querés atacar a tu enemigo, conócelo”.
Un dispositivo para observar el comportamiento de las células cancerosas
Para entender cómo actúan las células cancerosas en el momento que se separan del resto con el objetivo de buscar otros lugares del cuerpo donde continuar extendiendo su daño, la científica argentina Sofia Merajver, directora científica del programa de cáncer de mama de la Universidad de Michigan, logró desarrollar junto a su equipo un pequeño dispositivo que permite cultivar y poder observar el comportamiento de esas células."Es especialmente importante poder capturar esas células líderes y entender su biología - ¿porqué son tan exitosas, por qué son resistentes a la quimioterapia tradicional y cómo podemos atacarlas selectivamente", dice la autora del estudio Sofia Merajver, científica argentina, directora científica del Programa de cáncer de mama en la Universidad de Michigan Comprehensive Cancer Center.
"Los dispositivos microfluídicos nos están ayudando a entender la biología que antes no era accesible", agrega.
El problema, hasta ahora, era que en los dispositivos disponibles las células no duraban el tiempo suficiente, por lo que sólo servían para experimentos de corta duración. En el caso del cáncer, que los procesos llevan más tiempo, se necesitaba un dispositivo que permitiera cultivas células durante periodos de tiempo más largo y así poder identificar a estas “células líderes” que son las que se separan del grupo y viajan a otros órganos. Este dispositivo resultó ser estable hasta por lo menos tres semanas, lo que amplía la ventana de observación de las células. El trabajo fue publicado en Scientific Reports.
"Este dispositivo es una combinación de trata de entender a nivel fundamental y descubrir, un nuevo objetivo: moléculas para atacar al cáncer. Al mismo tiempo no había forma de tener las células de paciente y ponerlas en un dispositivo muy barato y fácil de criarlas por mucho tiempos. Esto es muy distinto a intentos anteriores, porque se pueden mantener las células hasta por dos semanas. Se puede observar muy detalladamente su comportamiento", explica la doctora Merajver a Clarín.
“Muchos procesos tumorales como la invasión y la resistencia no ocurren de la noche a la mañana”, afirma Koh Meng Aw Yong, becario postodoctoral del laboratorio de Merajver y autor del estudio.
El equipo desarrolló un nuevo dispositivo fluídico que les permitió cultivar células durante períodos más largos de tiempo. Los investigadores encontraron que el dispositivo era estable hasta al menos tres semanas en cultivo.
El dispositivo consta de tres canales pequeños a través del cual fluyen las células, a diferencia de los dispositivos de fluidos típicos que las mantiene en dos dimensiones. Las células se introducen en un canal y el fluido fluye a través de un canal paralelo para proporcionar presión y flujo sin perturbar al cultivo. El flujo de fluido a través del canal exterior imita lo que sucede con los capilares del cuerpo.
Ello permite a los investigadores añadir las células cancerosas en el dispositivo con una mínima perturbación o cambios a las células.
Los investigadores probaron el dispositivo con dos líneas de células de cáncer de próstata metastásico, pudiendo aislar las células líder -aquellas células que se separaron primero para viajar a órganos distantes.
Después de dos semanas, encontraron que las células de una línea eran dos veces más invasivas que una célula en otra línea. Pero después de tres semanas, la diferencia había desaparecido, sugiriendo que el potencial invasivo de las células puede cambiar con el tiempo.
“El dispositivo también tiene potencial para ser utilizado para probar fármacos y detectar cuando el cáncer se vuelve resistente. Esto permitiría a los oncólogos a saber más rápido si una terapia no está funcionando, y tal vez dar al paciente otra opción”, dijo el autor principal del estudio Jianping Fu, profesor asociado de ingeniería mecánica en la Universidad de Michigan. “Por supuesto, se necesita más investigación para explorar esta posibilidad en el futuro.”
Investigadores platenses desarrollan medicamentos para tratar la Tuberculosis
La Unidad de Producción de Medicamentos (UPM) de la Facultad de Ciencias Exactas de la UNLP logró la aprobación de la Administración Nacional de Medicamentos, Alimentos y Tecnología Médica (ANMAT), de seis lotes de medicamentos para el tratamiento de la Tuberculosis (TBC) que beneficiará a más de 20 pacientes en el país.
Frente a un escenario de crisis sanitaria, y a pedido del ministerio de Salud, en sólo 27 semanas la UPM desarrolló 8 medicamentos, realizó la transferencia de 6 de estos desarrollos a una planta farmacéutica, e hizo el seguimiento de los procesos productivos y controles de calidad, que permitieron elaborar más de 5 millones de comprimidos.
La tuberculosis, una enfermedad que se creía erradicada, reemergió hace 4 o 5 años, y la cantidad de personas afectadas crece a un ritmo preocupante, aunque siguen siendo un sector minoritario de la población.
El trabajo llevado adelante en los laboratorios de la UNLP fue articulado con el laboratorio Prozome, de Viedma, para atender una falta de stock de 8 meses. Si bien podía producirlo a escala, en millones de comprimidos, no se encontraba en condiciones de desarrollarlos y no disponían de las fórmulas ni de los procedimientos de elaboración.
“Pudimos elaborar, con el Laboratorio Prozome de Viedma, más de 5 millones de comprimidos y cubrir esa necesidad de la sociedad, es decir, cubrir una demanda que el sector privado no atiende”, sostuvo Arturo Hoya, Director Técnico de la UPM.
El investigador agregó, además, que “para los laboratorios privados no resultaba atractivo producir estos fármacos por tratarse ser un nicho muy pequeño y de una serie de medicamentos de bajo costo que no les rinden económicamente. A eso se denomina “orfandad”: no está el medicamento que se requiriere y el sector privado no lo produce”.
En este contexto, la universidad pública cumplió un rol fundamental para la Salud Pública y en su faceta extensionista aportó el conocimiento necesario para llevar adelante la producción de medicamentos, dando una solución a la crisis sanitaria que se planteó a nivel nacional.
Unidad de Producción de Medicamentos
La UPM es un laboratorio de Investigación y Desarrollo de medicamentos que cuenta con equipamiento de última generación. Sus principales actividades están dirigidas al desarrollo integral de medicamentos, es decir, optimizar las fórmulas y procedimientos de elaboración y estabilidad, para luego transferir esos desarrollos a plantas de producción en gran escala.
Este ha sido el caso de los medicamentos para la tuberculosis, donde la UPM no sólo hizo los desarrollos, sino también la transferencia de los procesos a escala industrial y los controles de calidad de los lotes productivos que fueron elaborados en una planta farmacéutica.
“La UNLP cuenta con la estructura y los recursos necesarios para realizar el desarrollo de medicamentos, el control de calidad y para hacer los seguimientos en los procesos productivos. Esto último se lleva a cabo articulando en forma constante con plantas farmacéuticas de producción estatal, como el mencionado PROZOME de Río Negro, el Instituto Biológico de La Plata y el LIF, el Laboratorio Industrial Farmacéutico, de Santa Fe, entre otros”, resaltó Arturo Hoya.
La segunda fase de producción de los medicamentos para tratar la tuberculosis se prevé para septiembre de 2017. En los próximos años se seguirán produciendo, seguramente en una menor cantidad. Este conocimiento transferido por la UNLP pasará a formar parte de ese laboratorio público.
Eduardo Spinola
Esta dirección de correo electrónico está siendo protegida contra los robots de spam. Necesita tener JavaScript habilitado para poder verlo.
Dirección General de Comunicación Institucional de la UNLP
Dirección General de Comunicación y Medios
Estimular las células grasas de la médula ósea mediante un antidiabético suprimiría la leucemia
Según un nuevo estudio de investigadores del Instituto de Investigación sobre Células Madre y Cáncer de la Universidad McMaster, en Ontario, Canadá, se descubrió que estimular los adipocitos o las células grasas, ubicados en el interior del hueso, suprimía las células de la leucemia cancerosa pero, en una sorpresa para el equipo, los científicos indujeron la regeneración de células sanguíneas sanas al mismo tiempo, como se detalla en un artículo publicado en Nature Cell Biology.
La producción de glóbulos rojos sanos es crítica para aquellos con leucemia mieloide aguda, pero a veces se pasa por alto, ya que los tratamientos convencionales se centran en matar las células de la leucemia solo. Los pacientes con esta enfermedad sufren de anemia e infección debido al fracaso de la producción de sangre saludable, todos los cuales son las principales causas de hospitalización y muerte por la enfermedad.
“Nuestro enfoque representa una forma diferente de observar la leucemia y considera a la médula ósea entera como un ecosistema, en lugar del enfoque tradicional de estudiar e intentar matar directamente a las células enfermas”, explica la primera autora del estudio, Allison Boyd, investigadora postdoctoral del Instituto de Investigación. “Estos enfoques tradicionales no han brindado suficientes nuevas opciones terapéuticas para los pacientes. El estándar de atención para esta enfermedad no ha cambiado en varias décadas”, añade.
Es trabajo se realizó durante los últimos tres años y medio y comenzó a partir de observaciones de pacientes con leucemia, lo que condujo a la recolección de muestras de médula ósea de cohortes más grandes de pacientes con el Instituto de Investigación Hospitalario de Ottawa, así como las de Western University y Hamilton Health Sciences, para los próximos pasos de investigación.
Un fármaco antidiabético estimula la producción de glóbulos rojos
Los investigadores realizaron un estudio detallado y compararon imágenes de las células de leucemia individuales con las células sanas que residen en la médula ósea, lo que reveló los efectos de centrarse en las células de grasa. Se usó un fármaco comúnmente empleado para moderar la diabetes que induce la producción de células grasas en la médula ósea y se descubrió que ayuda a fomentar la fabricación de glóbulos rojos, así como a suprimir la enfermedad leucémica.
“El enfoque de la quimioterapia y el estándar de atención existente está en la eliminación de células cancerosas, pero adoptamos un enfoque completamente diferente que cambia el entorno en que viven las células cancerosas”, explica el director del equipo de investigación, Mick Bhatia, director y científico principal en células madre de McMaster y el Instituto de Investigación del Cancer. “Esto no solo suprimió las células cancerosas ‘malas’, sino que también reforzó las células sanas ‘buenas’ permitiéndoles regenerarse en el nuevo ambiente inducido por los fármacos. El hecho de que podemos apuntar a un tipo de célula en un tejido usando un fármaco existente nos entusiasma con la posibilidad de probar esto en pacientes”, añade.
Y concluye: “Podemos imaginar que esto se convierte en un potencial nuevo enfoque terapéutico que puede agregarse a los tratamientos existentes o, incluso, reemplazar a otros en el futuro cercano. El hecho de que este medicamento active la regeneración de la sangre puede proporcionar beneficios para aquellos que esperan trasplantes de médula ósea al activar sus propios células sanas”.
Fuente:
| Redacción Médica España |
Investigadores del Conicet probarán nuevo protocolo contra el cáncer de páncreas
Utilizará la quimioterapia habitual y sumará el uso de dos drogas, una de las cuales se encuentra en proceso de aprobación por parte de la Administración Nacional de Medicamentos, Alimentos y Tecnología Médica (ANMAT), y el otro es utilizado para tratar afecciones cardíacas.
“Estas dos drogas se administran por vía oral y prácticamente no tienen toxicidad, incluso si el paciente no responde al tratamiento tradicional podrá seguir recibiendo las dos drogas”, indicó Graciela Scharovsky, investigadora principal del Conicet y directora del equipo.
Viviana Rozados, también integrante del equipo investigador, señaló que “si bien no es un número de casos muy elevado, de acuerdo a los resultados que obtengamos podemos plantear nuevos proyectos que permitan aumentar el número de personas tratadas”.
En este proyecto, el equipo de la Facultad de Ciencias Médicas trabajará en colaboración con investigadores de la Facultad de Ciencias Bioquímicas y Farmacéuticas y con oncólogos del Hospital Provincial del Centenario, conformando un grupo interdisciplinario y multiinstitucional.
El nuevo protocolo que aplicarán forma parte de una línea de investigación sobre quimioterapia metronómica y reposicionamiento de fármacos que el equipo de Scharovsky viene desarrollando desde hace más de quince años.
La quimioterapia metronómica consiste en la administración de drogas de uso común en el tratamiento del cáncer, a intervalos regulares, en forma crónica y sin períodos prolongados de descanso, pero en dosis mucho más bajas que las indicadas normalmente.
Este tipo de quimioterapia tiene el doble beneficio de no causar efectos secundarios debido a la baja toxicidad de las dosis y, por otro lado, de impedir que las células malignas proliferen por ser administrada crónicamente.
Fuente: Presidencia de la Nación
ANMAT crea un un programa de becas de investigación en ciencia reguladora
|
Disposición 10451-E/2017 – ANMAT |
| VISTO la Ley de Medicamentos Nro. 16.463, el Decreto Nro. 1490 de fecha 20 de agosto de 1992 y 1271 de fecha 29 de agosto de 2013; la Disposición ANMAT N° 4548 de fecha 1° de julio de 2014 y el Expediente N° 1-0047-0000-005083-17-4 del Registro de esta ADMINISTRACIÓN NACIONAL DE MEDICAMENTOS, ALIMENTOS Y TECNOLOGÍA MÉDICA (ANMAT), y CONSIDERANDO: Que por Decreto Nº 1490/92, se creó en el ámbito de la ex SECRETARÍA DE SALUD del MINISTERIO DE SALUD y ACCIÓN SOCIAL, esta ADMINISTRACIÓN NACIONAL DE MEDICAMENTOS, ALIMENTOS Y TECNOLOGÍA MÉDICA (ANMAT), como organismo descentralizado de la Administración Pública Nacional, con jurisdicción en todo el territorio de la Nación, asumiendo las funciones referidas al control y fiscalización sobre la sanidad y calidad de las drogas, productos químicos, reactivos, formas farmacéuticas, medicamentos, elementos de diagnóstico, materiales y tecnologíabiomédicos y todo otro producto de uso y aplicación en la medicina humana; (Artículos 2° y 3º, inciso a). Que las normas aludidas tienen como finalidad última la protección de la salud de la población, mediante la adopción de un modelo fiscalizador de gestión que destina los mayores esfuerzos a garantizar la eficacia, seguridad y calidad de los productos que consume la población. Que asimismo entre sus atribuciones se encuentra la de Implementar acciones de investigación, asistencia técnica, docencia, capacitación, promoción, comunicación, difusión y toda otra actividad orientada a prevenir y resguardar la salud de la población (Artículo 8° inciso h) Que en su artículo 10° inciso k) se estableció expresamente la facultad de programar e implementar actividades de docencia, investigación, capacitación y asistencia técnica en relación con las materias sujetas a la competencia del Organismo, así como otorgar becas para estudios, investigaciones y especializaciones. Que la investigación científica en un campo particular tiene como objetivo la generación de nuevo conocimiento, del cual se desprenden principios y leyes con capacidad predictiva, lo cual resulta esencial para la toma de decisiones en los ámbitos correspondientes. Que en una agencia reguladora la investigación científica tiene como meta desarrollar nuevos métodos, herramientas, criterios, estándares y reglamentaciones que le permitan ejercer de mejor manera sus acciones y así alcanzar con éxito sus objetivos. Que por los motivos mencionados precedentemente, la investigación que se realiza en una agencia reguladora, tiene un carácter profundamente traslacional y de alto impacto, dado que constituye una herramienta esencial para asegurar que los ciudadanos cuenten con productos eficaces, seguros y de calidad. Que dado el carácter dinámico de la generación de nuevo conocimiento en los campos ligados a la medicina y la salud humana, y en especial en el desarrollo de nuevas tecnologías, esta Administración constantemente se impone el desafío de estar al frente de tales avances, de manera de contar con herramientas útiles para ejercer sus acciones de evaluación, registro, fiscalización, control, vigilancia y normalización relativos a la producción y comercialización de estos productos innovadores, así como propiciar el desarrollo de estas nuevas tecnologías para el bienestar de la población. Que esta Administración ha sido reconocida como miembro del Comité Ejecutivo de la “Coalición Global para la Investigación en Ciencia Reguladora”, en la cual intervienen diversas agencias reguladoras de amplio reconocimiento internacional, y entre cuyos objetivos se destacan los de promover y desarrollar la investigación, apoyar la toma de decisiones regulatorias de manera global y establecer las mejores prácticas para comprender e interpretar la información acerca de las nuevas tecnologías. Que la ciencia reguladora consiste en la utilización, en cada acto decisorio, de la mejor evidencia científica disponible, como resultado de la convergencia de profesionales, académicos, reguladores y la sociedad en su conjunto. Que las normas citadas en el VISTO, hacen especial hincapié en la conveniencia y necesidad de desarrollar y promover la investigación científica en temas de relevancia para el organismo. Que el otorgamiento de becas de investigación es un sistema ampliamente extendido en nuestro país y en todo el mundo, cuyo objetivo principal es fomentar la investigación científica y apoyar la formación de jóvenes científicos. Que la creación de una beca de investigación en ciencia reguladora tiene un carácter totalmente novedoso y fomenta la formación posgrado de alta calidad en un campo aplicado de la ciencia con amplia trascendencia en salud pública. Que esta Administración, organismo nacional de referencia en la materia, constituye un ámbito altamente adecuado y propicio para el desarrollo de investigaciones de carácter regulatorio. Que desde su creación esta Administración ha ejercido un rol docente reconocido y ha contribuido ampliamente a la capacitación de posgrado. Que la creación de una “Beca de Investigación en Ciencia Reguladora” en el ámbito de esta Administración, contribuye a alcanzar ambos objetivos de propiciar la investigación regulatoria y la formación de profesionales especialistas en temáticas regulatorias relevantes. Que la Dirección de Recursos Humanos y Organización, la Dirección General de Administración y la Dirección General de Asuntos Jurídicos han tomado la intervención de su competencia. Que se actúa en ejercicio de las facultades conferidas por el Decreto Nº 1490/92 y el Decreto N° 101 de fecha del 16 de diciembre de 2015. Por ello; EL ADMINISTRADOR NACIONAL DE LA ADMINISTRACIÓN NACIONAL DE MEDICAMENTOS, ALIMENTOS Y TECNOLOGÍA MÉDICA DISPONE: ARTÍCULO 1º.- Créase en el ámbito de esta Administración Nacional de Medicamentos, Alimentos y Tecnología Médica un programa de “BECAS DE INVESTIGACIÓN EN CIENCIA REGULADORA” destinado a propiciar el desarrollo científico en el organismo y apoyar la formación profesional en áreas de investigación científica regulatoria de productos para la salud. ARTÍCULO 2°.- El desarrollo de la beca se enmarcará dentro de un proyecto de investigación con fines regulatorios, el cual se desarrollará en unidades organizativas no inferiores a direcciones de esta Administración y será responsabilidad de la autoridad máxima de dicha dirección. ARTÍCULO 3º.- La “BECA DE INVESTIGACIÓN EN CIENCIA REGULADORA” será de dos tipos, de acuerdo a los objetivos de cada proyecto: - Beca tipo A: de dos (2) años de duración, podrá extenderse por un (1) año adicional previa aprobación por parte de los responsables del programa. - Beca Tipo B: de tres (3) años de duración, podrá extenderse por dos (2) años adicionales, previa aprobación por parte de los responsables del programa. ARTÍCULO 4º.- Con el objetivo de propiciar su participación, el becario recibirá un estipendio mensual en carácter de “ayuda económica e incentivo”, cuyo monto será fijado para cada convocatoria. ARTÍCULO 5°.- La organización y supervisión general del programa de becas estará a cargo de la COORDINACIÓN DE CAPACITACIÓN E INVESTIGACIÓN CIENTÍFICA SANITARIA de la DIRECCIÓN DE RECURSOS HUMANOS Y ORGANIZACIÓN. ARTÍCULO 6°.- Apruébase el “Reglamento de la Beca de Investigación en Ciencia Reguladora”, que como Anexo I forma parte de la presente disposición y que consta como documento IF-2017-22982152- APN-DRRHHYO#ANMAT. ARTÍCULO 7°.- Apruébase el modelo de “CONVENIO anmat - becario” de la “Beca de Investigación en Ciencia Reguladora”, que como Anexo II forma parte de la presente disposición y que consta como documento IF-2017-22982037-APN-DRRHHYO#ANMAT. ARTÍCULO 8°.- Regístrese; comuníquese a la Dirección de Recursos Humanos y Organización. Dése a la Dirección Nacional del Registro Oficial para su publicación; cumplido, archívese. — Carlos Alberto Chiale. NOTA: El/los Anexo/s que integra/n este(a) Disposición se publican en la edición web del BORA -www.boletinoficial.gob.ar- y también podrán ser consultados en la Sede Central de esta Dirección Nacional (Suipacha 767 – Ciudad Autónoma de Buenos Aires). e. 11/10/2017 N° 76514/17 v. 11/10/2017 |
Equipo de científicos rosarinos avanza contra las superbacterias
Otra vez, una investigación realizada por un equipo del Instituto de Biología Molecular y Celular de Rosario (IBR, Conicet, UNR) logró un gran avance en la lucha contra las llamadas “superbacterias“, responsables del fallecimiento anual de unas 700 mil personas en el mundo y que se cree podrían llegar a ser primera causa de muerte en el 2050. El descubrimiento, publicado hace unos días por la prestigiosa revista científica internacional Nature Communications, abre las puertas para el “diseño racional de fármacos” capaces de frenar el avance de esas infecciones letales, explicó ayer a LaCapital el titular del IBR y uno de los codirectores del grupo, Alejandro Vila.
Dar pelea a las superbacterias es actualmente uno de los desafíos más acuciantes para la ciencia. De hecho, en febrero pasado fue la propia Organización Mundial de la Salud (OMS) la que reavivó la preocupación internacional al difundir el listado de las doce familias de bacterias causantes de infecciones severas que los actuales tratamientos no logran vencer y que dejan a cada vez más población sin terapias efectivas.Ocurre que las superbacterias son microorganismos que desarrollan una multirresistencia a los antibióticos, aun a los de mayor potencia y eficacia, y que vienen generando un alarmante crecimiento en la tasa de infectados sobre todo a nivel intrahospitalario en todo el mundo. De allí que el nuevo avance de los científicos del IBR sobre la materia cobre tanta trascendencia.El trabajo, codirigido por Vila y Leticia Llarull, fue producto de las “contribuciones centrales” que realizaron las jóvenes investigadoras María Natalia Lisa y Antonela Palacios.
Al estudio también hicieron aportes, en colaboración con científicos de Estados Unidos y el Reino Unido, Mariano González (IBR) y Diego Moreno (Instituto de Química Rosario, Iquir).
Un hito revolucionario
La penicilina, descubierta en 1928 por Alexander Fleming, cambió el rumbo de la historia. El posterior desarrollo de numerosos antibióticos similares a la penicilina, llamados betalactámicos, obtenidos tanto a partir de fuentes naturales como de síntesis químicas, no sólo permitió salvar millones de vidas en la Segunda Guerra Mundial, sino que resultó determinante para la prolongación de la expectativa de vida en el siglo XX.
Sin embargo, esos avances ahora muestran su contracara: el uso excesivo e indebido de esos medicamentos dio lugar a la selección de bacterias cada vez más resistentes, hoy conocidas como superbacterias.
A ellas apuntó la investigación que acaba de publicar Nature Communication y que, producto de un trabajo de ocho años, básicamente logró poner al descubierto los mecanismos químicos que utilizan esas bacterias para “inactivar antibióticos de última generación”.
De hecho, pudo demostrar que varias especies de esos microorganismos poseen similares mecanismos de resistencia, por lo que se abre la posibilidad de producir tratamientos efectivos para un amplio espectro bacteriano. “Es decir, no uno para cada bacteria, sino un fármaco general”, explicó Vila.
Se trata de un nuevo “paso clave” para combatir las superbacterias resistentes incluso a la acción simultánea de varios antibióticos y que han alcanzado una “diseminación global”, enfrentando a la humanidad a una “situación sin precedentes”: no poder vencer infecciones que hasta ahora venían siendo tratables.
Pero para poder diseñar nuevos fármacos hay que conocer “las estrategias químicas de defensa” de las bacterias o la estructura de las moléculas involucradas.
Para sobrevivir a la acción de los antibióticos betalactámicos, uno de los principales mecanismos que usan las bacterias es la producción de unas enzimas capaces de degradarlos, llamadas betalactamasas.
Existe una clase de antibióticos, los carbapenemes, capaces de resistir a esas enzimas, por lo que representan “la última línea de defensa disponible frente a infecciones causadas por bacterias multirresistentes”. Sin embargo, esas bacterias evolucionaron y muchas ya logran sobrevivir a esas drogas.
Por eso el trabajo del equipo del IBR abre ahora puertas hacia nuevas líneas de investigación en el diseño racional de fármacos (ver aparte).
La multiplicación de bacterias resistentes a los antibióticos amenaza con volverse primera causa de muerte en 2050.
| Avances que se dan de a poco | ||
| Hace poco más de un año, en el IBR ya habían cosechado otro gran logro científico contra las superbacterias. En esa oportunidad la investigación, también dirigida por Alejandro Vila y realizada junto a los investigadores Lisandro González y Guillermo Bahr, apuntó a una enzima, denominada NDM, responsable de la destrucción de los antibióticos. | ||
|
|
||
| Hace poco más de un año, en el IBR ya habían cosechado otro gran logro científico contra las superbacterias. En esa oportunidad la investigación, también dirigida por Alejandro Vila y realizada junto a los investigadores Lisandro González y Guillermo Bahr, apuntó a una enzima, denominada NDM, responsable de la destrucción de los antibióticos.El estudio descubrió que la NDM está anclada a la membrana de la pared celular y desde allí envía vesículas de grasa al exterior de la célula. Ese mecanismo le permite frenar la acción de los medicamentos y, al entrar en contacto con otras bacterias, las vuelve también resistentes a los antibióticos, multiplicando el efecto.El logro, se anunció entonces, permitiría identificar con una prueba de muy bajo costo la presencia de esa enzima en personas enfermas y orientar el tratamiento con los antibióticos más adecuados.
Ayer Vila contó que se trata de “avances paso a paso” y adelantó que ya están trabajando en un “equipo internacional” junto a científicos de Estados Unidos, Reino Unido y Uruguay para llegar a producir “compuestos” dirigidos al diseño de nuevos fármacos. |
Cilastatina, el primer protector del riñón
Tras cerca de una década de investigación pueden decir que han dado con el primer medicamento que actúa como protector del riñón.
Hasta ahora, la única forma que tenían los médicos de evitar que los fuertes medicamentos contra el cáncer, el sida o el rechazo de trasplantes dañaran el riñón era hidratar mucho al enfermo, «pero no existe hasta el momento ninguna molécula protectora», afirmó ayer Alberto Tejedor, responsable del servicio de Nefrología del Hospital Gregorio Marañón de Madrid y que dirige un equipo de diez investigadores del Laboratorio de Fisiopatología Renal. Tras cerca de una década de investigación pueden decir que han dado con el primer medicamento que actúa como protector del riñón.
Fármacos como el cisplatino, uno de los más potentes contra el cáncer; los inmunosupresores que evitan el rechazo de trasplantes; los medicamentos contra el sida e, incluso, algunos antibióticos tienen elementos tóxicos que dañan el riñón y pueden producir fracaso renal agudo. Una patología que conocen bien los médicos. «Se produce en el 7 por ciento de los pacientes hospitalizados y en entre el 36 y el 67 por ciento de los enfermos críticos», explica Tejedor. De ahí que sea tan importante el descubrimiento. Es más, «puede reducir la función del riñón para el resto de sus vidas», añade.
El hallazgo de la cilastatina tiene algo de azar. «Este compuesto formaba parte de una formulación antigua que se utilizaba con un antibiótico», sostiene Tejedor. El medicamento del que procede es el Tienam, que se utilizaba en los años 90 para tratar las infecciones de orina. Tras analizar varios estudios en los que se utilizaba la cilastatina, los científicos del Gregorio Marañón decidieron dar el paso y probar su eficacia en placas de cultivo. «Para nuestra sorpresa a medida que íbamos probando la combinación de la cilastatina con los fármacos nefrotóxicos, comprobábamos cómo las células no se despegaban y morían, sino que sobrevivían», asevera Alberto Lázaro, director científico del Laboratorio. A eso se suma que «no quita eficacia terapéutica», añade. Así, como explican los investigadores, no es que la cilastatina sea capaz de evitar que se produzca el daño renal primario, sino que «lo que conseguimos es que no se expanda al resto de células». Es como el “omeoprazol” del riñón, ya que actúa de protector.
La siguiente fase fue determinar si también funcionaba en animales. Tras este hallazgo, fue a la biofarmacéutica Spherium Biomed a quien licenciaron la patente. En 2018 se empezará a probar en pacientes y «esperamos que en año y medio pueda estar disponible».
Fuente: La Razón – España
Científicos argentinos ganan el mayor subsidio de investigación básica de la Unión Europea
Integran un consorcio con colegas europeos para estudiar un tipo de proteínas asociadas con el cáncer, enfermedades neurodegenerativas y virales.
Un consorcio de instituciones científicas de Argentina fue elegido por el programa de investigación básica más grande de la Unión Europea (UE) para estudiar, junto con colegas europeos y mediante métodos computacionales, cierto de tipo de proteínas que podrían estar involucradas en la génesis de numerosas enfermedades, incluyendo el cáncer, el Parkinson, el Alzheimer y las infecciones virales.
Grupos de bioinformáticos del Instituto Leloir, de la Universidad Nacional de Quilmes (UNQ) y de la Universidad Nacional de San Martín (UNSAM) recibirán casi un millón y medio de euros otorgados por la Comisión Europea a través del prestigioso Programa Marco de Innovación e Investigación Horizonte 2020 y la Acción Marie Sklodowska-Curie para la promoción de la ciencia. Ese monto se compartirá con colegas de la Universidad de Padua, en Italia; de la Universidad Eötvös Loránd, en Hungría; del University College de Dublin, en Irlanda; y del Laboratorio Europeo de Biología Molecular, conformado por centros de investigación de 18 países del continente.
Las proteínas que se van a investigar son las llamadas “intrínsecamente desordenadas” o IDP según sus siglas en inglés, “un tipo de moléculas que despierta interés dentro de la comunidad científica porque hay evidencia creciente de que, entre otras cosas, se asocian con numerosas enfermedades”, indica la doctora Cristina Marino-Buslje, jefa del Laboratorio de Bioinformática Estructural en el Instituto Leloir e investigadora del Conicet en el Instituto de Investigaciones Bioquímicas de Buenos Aires (IIBBA, CONICET – Instituto Leloir).
Las proteínas, además de cumplir un rol estructural, aceleran reacciones químicas esenciales, regulan la expresión de la información genética, posibilitan la comunicación entre células y transportan nutrientes, entre otras funciones vitales para el organismo.
Dentro de esa categoría de moléculas, las IDP son un tipo particular que desafía el paradigma clásico establecido por el bioquímico estadounidense Christian Anfinsen, Nobel de Química 1972, una proteína posee una única estructura tridimensional que determina su función. En realidad, de acuerdo con estimaciones recientes, más del 30% de las proteínas son muy flexibles y tienen regiones plásticas que cambian constantemente de conformación y pueden interactuar de manera compleja y a veces “promiscua” con otras proteínas. Los mecanismos de esta versatilidad molecular son poco conocidos.
“Antes se pensaba que las proteínas eran objetos rígidos como pelotas de fútbol. Hoy sabemos que debemos imaginarlas como moléculas a veces muy flexibles, cuyos movimientos son fundamentales para su función”, señala la doctora Lucía Chemes, jefa del Laboratorio de Biofísica de Proteínas y Motivos Lineales del Instituto de Investigaciones Biotecnológicas (IIB), que depende de la UNSAM e investigadora del CONICET.
El consorcio va a enfocar sus esfuerzos en avanzar en metodologías para identificar estas proteínas desordenadas en los genomas de las células humanas y también las de patógenos microbianos y virales. “Estamos muy entusiasmados por esta posibilidad –dice Chemes–. La oportunidad que nos presenta el subsidio es única, ya que permite combinar y reunir las capacidades de múltiples expertos en disciplinas experimentales y bioinformáticas para avanzar en nuestra comprensión de la función de esta clase de proteínas. Y este conocimiento podría permitir en el futuro el desarrollo de terapias innovadoras contra muchas enfermedades”.
Asimismo Marino-Buslje afirmó que “investigar este tipo de proteínas implica conocer una nueva biología. Y también permitirá eventualmente desarrollar mejores herramientas computacionales para su estudio”.
Fuente: Agencia CyTA-Leloir
Mujeres con gingivitis crónica tienen más chances de padecer cáncer
Las mujeres que en la menopausia sufren una infección gingival crónica, tienen un 14% más chances de desarrollar cáncer, especialmente de esófago.
La investigación se llevó a cabo entre 1999 y 2013 e involucró a 65 mil mujeres.
Los investigadores, cuyo trabajo fue publicado en la revista médica “Cancer Epidemiology, Biomarkers and Prevention”, también constataron que esas mujeres tenían un riesgo significativamente mayor de padecer cáncer de pulmón, mama, vesícula biliar y melanoma, un tumor agresivo de piel.
El estudio fue realizado entre 1999 y 2013, con más de 65 mujeres de edad entre 54 y 86 años, que respondieron un cuestionario sobre su salud durante un período promedio de control de 8 años.
Estudios anteriores habían sugerido que las personas que padecen enfermedad periodontal eran más propensas a desarrollar ciertos tipos de cáncer.
Pero este estudio es el primero en concentrarse específicamente sobre esta infección crónica de las encías para todos los tipos de cáncer en una población de mujeres mayores, expresó Jean Wactawski-Wende, principal autor del estudio e investigador de la Facultad de Salud Pública de la Universidad del Estado de Nueva York, en Búfalo.
En tanto, más estudios serán necesarios para determinar exactamente cómo la enfermedad periodontal puede provocar cáncer, dijo el científico.
Según una hipótesis, las bacterias de la placa bacteriana o la saliva podrían acabar ingresando en la corriente sanguínea.
El mayor riesgo de cáncer de esófago podría explicarse por su proximidad con la boca, afirmó Wactawski-Wende.
La enfermedad periodontal afecta al diente y destruye los tejidos de apoyo, encía y hueso. Esta patología es bastante lenta y evoluciona a lo largo de varias décadas.
Fuente: Folha de Sao Paulo – Brasil
Investigador argentino logra producir anticuerpos humanos
El avance podría facilitar el desarrollo de nuevas vacunas, al permitir producir anticuerpos más rápidamente in vitro. Ayudaría a combatir enfermedades infecciosas y otras como el cáncer.
Un grupo de investigadores ha logrado un método para desarrollar rápidamente anticuerpos humanos específicos en el laboratorio que puede ayudar a combatir enfermedades infecciosas y otras como el cáncer, según un artículo divulgado este lunes en la revista Journal of Experimental Medicine. Este hallazgo podría acelerar la producción de anticuerpos para tratar un amplio espectro de enfermedades y facilitar el desarrollo de nuevas vacunas, indicaron los científicos.
La investigación fue liderada por el doctor argentino Facundo Batista, del Francis Crick Institute de Londres. “En particular, debería permitir la producción estos anticuerpos en un periodo de tiempo más corto in vitro y sin la necesidad de vacunación o donación de sangre de personas recientemente infectadas”, apuntó Batista.
Actualmente, el método de desarrollo de vacunas implica la toma de muestras de la enfermedad y la creación de un antígeno mediante el crecimiento de los virus en células primarias, lo que supone conseguir estas muestras de donantes infectados y aislar luego el antígeno de las células usadas para crearlo.
Fragmentos de ADN
Los investigadores liderados por Batista han logrado replicar este proceso en el laboratorio al producir anticuerpos específicos de estas células aislados de las muestras de sangre. Sin embargo, y además del encuentro con un antígeno concreto, las células necesitan una segunda señal para empezar a desarrollar estos anticuerpos, algo que puede conseguirse por pequeños fragmentos de ADN llamados CpG oligonucleótidos, que activan una proteína llamada TLR9. Para ello, los científicos consiguieron producir anticuerpos específicos gracias al tratamiento de células impregnadas con nanopartículas con CpG oligonucleótidos y el antígeno apropiado en unos pocos días en el laboratorio. Como consecuencia, el procedimiento no depende de que los donantes hayan sido expuestos a estos antígenos previamente, y se logró como ejemplo generar anticuerpos contra el HIV desde células aisladas por pacientes sin HIV.
Fuente: 20 Minutos – España
Lo más visto
- Covishield, la vacuna que India lanzó con Oxford-AstraZeneca
- El gobierno establece los requisitos para la producción de cannabis medicinal
- Anmat aprobó en el país la primera vacuna que protege contra el dengue
- Ibupirac declarado apto para celíacos
- Comunicación de Novo Nordisk: Diferencias en la indicación de Victoza® y Saxenda®